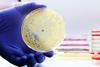
The,Rise,Of,Antibiotic-resistant,Bacterial,Infections.,Super,Bugs.,A,Microbiological

All Pathogens & microbiology articles
-
 Webinar
WebinarFrom ingredients to intelligence: building the data foundation for AI-driven food innovation
Most food R&D teams are running AI on a broken data foundation. Join this webinar to understand why and what idea-to-label looks like when the architecture is right.
-
 News
NewsUnsafe food causes 866 million illnesses and 1.5 million deaths annually, WHO reports
WHO estimates find unsafe food causes 866 million illnesses and 1.5 million deaths each year, with children and low-income regions hardest hit.
-
 News
NewsSalmonella cases hit decade high in England
UK food businesses face renewed food safety pressure as Salmonella and Campylobacter infections remain persistently high across England.
-
 Opinion
OpinionThe sustainability vs food safety quandry: saving the planet while risking food safety
Food safety and sustainability are inseparable, explains Professor Chris Elliott, noting the uncomfortable realisation that improvements to one often lead to weakness in the other. Read about why food safety frameworks must evolve alongside circular economy policies to realise the benefits of food innovation.
-
 News
NewsDubai Municipality launches advanced ViruGenetics Lab to detect foodborne viruses
Dubai Municipality has launched the ViruGenetics Lab at Dubai Central Laboratory, a first-of-its-kind facility in the UAE using digital PCR and genomic technologies to detect foodborne viruses with greater speed and precision, strengthening food safety and public health protection.
-
 Article
ArticleFrom spreadsheets to strategy: the high-stakes gamble of traditional supplier management
Supplier management processes are often manual and time-consuming, a high-stakes gamble that exposes your business to significant risk. Discover how a data-driven approach to supplier management can protect your brand, save thousands of administrative hours, and transform your due diligence from a reactive process into a strategic advantage. Read on to learn how to move from spreadsheets to strategy.
-
 News
NewsLargest-ever FDA testing of infant formula confirms low contaminant levels
Largest-ever FDA infant formula study finds most products meet high safety standards while regulators pledge tighter oversight and transparency.
-
 News
NewsGood4U recalls Super Sprouts Super Greens over Salmonella risk
Good4U recalls Super Sprouts Super Greens nationwide after potential Salmonella contamination, urging consumers to return affected packs with use-by dates up to 3 May.
-
 Article
ArticleTurning data into insight: GFSI panel examines AI’s role in food safety risk detection
Food safety leaders at GFSI Vancouver say AI and advanced analytics are transforming how companies detect and prevent risks across global supply chains.
-
 Article
ArticleHarnessing technology and innovation to ensure safe food for all
Technology is transforming food safety. Elizabeth Andoh-Kesson and Franck Pandiani of GFSI explain why digital tools, AI, and real-time data are now essential to protect consumers and streamline supply chains.
-
 Webinar
WebinarSmart food safety: implementing AI for risk, compliance and control
Join New Food and Dr Darin Detwiler as he lead an expert discussion on how AI is being implemented in food safety, from predictive risk modelling to real-world compliance systems.
-
 News
NewsDetecting trace pathogen levels does not always mean health risk, study finds
Researchers warn ultra-sensitive pathogen tests may trigger unnecessary recalls and food waste despite trace detections posing limited health risk.
-
 News
NewsEuropean Commission launches AI TraceMap tool to combat food fraud and outbreaks
The AI-powered TraceMap platform aims to speed detection of food fraud, contamination and outbreaks across EU agri-food supply chains.
-
 News
NewsNSF launches tiered UK food auditing service to support hygiene compliance
NSF unveils three-tier auditing programme to help UK hospitality and retail operators improve hygiene, manage risk and meet evolving regulations.
-
 News
NewsNanoplastics may increase Salmonella virulence, study warns
Researchers find nanoplastics from food packaging may boost Salmonella virulence and biofilm formation, raising emerging questions for food safety.
-
 News
NewsFDA upgrades frozen blueberries recall to Class I over listeria concern
More than 55,000 pounds of frozen blueberries recalled across US and Canada after listeria detection triggers highest-risk FDA action.
-
 Article
ArticleUnpacking the evolving science of pathogen persistence in food processing environments
Even the most robust sanitation programmes cannot fully eliminate pathogen persistence. As biofilms, harbourage sites and genomic surveillance reshape what manufacturers know about contamination risk, persistence is emerging as one of the defining tests of modern food safety.
-
 News
NewsEuropean Commission’s JRC launches certified reference material to improve cereulide toxin detection in food
JRC launches certified reference material to improve cereulide toxin measurement, helping laboratories enhance food safety testing and protect consumers worldwide.
-
News
NewsFoodborne antimicrobial resistance threat persists across Europe
EFSA and ECDC warn antimicrobial resistance in foodborne bacteria such as Salmonella and Campylobacter remains high, threatening treatment effectiveness and reinforcing need for coordinated food supply chain action.
-
 News
NewsFSA issues warning on safe handling of contaminated raw pet food
FSA survey finds harmful bacteria in raw pet food, prompting urgent safe handling guidance to protect pets, owners and vulnerable groups from infection.



